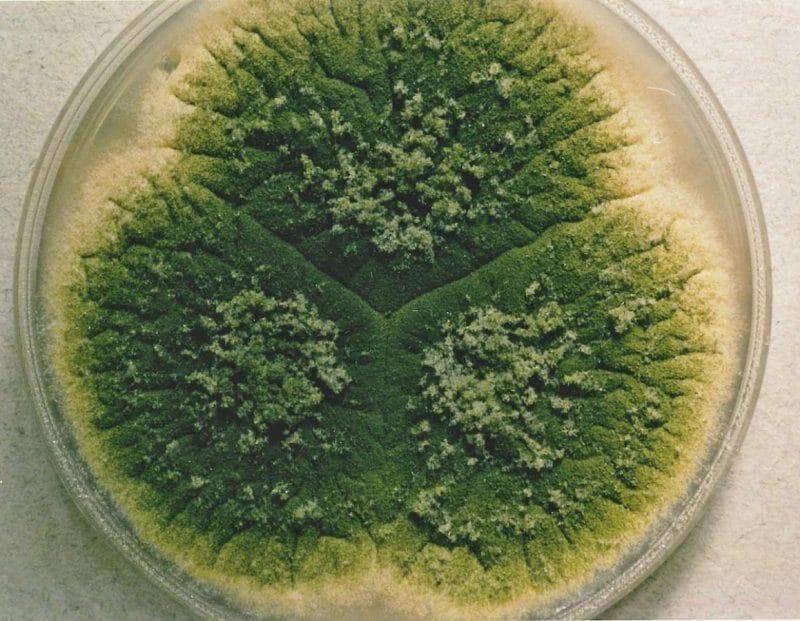
E’ allerta, richiamato dagli scaffali uno degli alimenti più consumati a Capodanno dagli italiani | Se avete questi lotti non consumateli!

Il Ministero della Salute svolge un ruolo fondamentale nella tutela della salute dei consumatori, monitorando i prodotti alimentari e avviando i necessari richiami. Recenti scoperte scientifiche hanno evidenziato l’importanza di gestire correttamente la contaminazione degli alimenti per prevenire gravi problemi di salute. E’ importante che il Ministero della Salute rimanga vigile per garantire che i […]